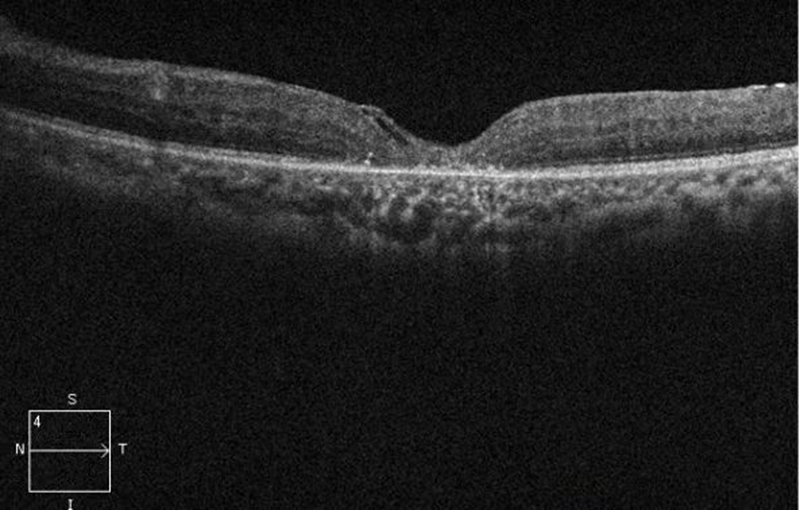
图片8.png

黔西南州人民医院眼科是贵州省重点扶持专科、黔西南州重点学科、国家住院医师规范化培训基地、遵义医科大学研究生联合培养单位。现为复旦大学附属眼耳鼻喉科医院眼视光学中心、上海市眼视光学研究中心眼视光联盟成员单位。上海市第九人民医院联盟单位。中国近视防控能力建设联盟骨干级单位。同时也是黔西南州眼科医疗质量控制中心、黔西南州近视眼防控中心、黔西南州近视眼手术治疗中心。黔西南州近视眼监测点、黔西南州儿童青少年近视眼防控健康宣教基地。

眼科目前拥有在职医护及技术人员共 48人,其中正高职称 6人(含硕士研究生导师 4人),副高职称9人,博士 2名,硕士研究生 6名;在多个学术团体担任重要职务:其中贵州省眼科学分会副主任委员1名、委员1名,青年委员2名;贵州省视光学会第一届委员会副主任委员1名、常委1名;贵州省眼科医疗质量控制中心委员2名;上海市眼视光学研究中心眼视光学联盟学术委员2名;中国微循环学会眼微循环专业委员会眼影像学组委员1名;中国女医师协会眼科专委会委员1名;贵州省医学会毕业后继续医学教育分会委员1名;贵州省医学会激光医学分会第四届委员会委员1名;中国康复医学会贵州干眼康复学组委员1名。州级各学会11名。现已形成具有自身特色和专科优势的学科,成为在省内具有一定影响力的眼科团队。在近视眼防治方面有充裕的人才保障。

眼科拥有全国一流的设备(其中部分设备全球领先)。先后引进了SMILE全飞秒3.0屈光手术系统、M90准分子手术系统、眼眶手术全套系统、UBM眼前节分析系统、德国海德堡OCT、电生理、YAG激光、角膜内皮显微镜、角膜地形图、德国海德堡联合造影机、德国蔡司IOLMaster 生物测量仪、法国光太眼底多点激光治疗仪。德国蔡司手术显微镜、日本拓普康手术显微镜、美国爱尔康超声乳化仪、美国眼力健白内障超声乳化仪、美国爱尔康CONSTELLATION玻璃体切割仪等一批先进的医疗设备。还拥有专的验光配镜中心。
眼视光诊疗 在全省地州级医院中,率先开展近视眼屈光手术。目前开展了SMILE全飞秒屈光手术、准分子激光手术、ICL及TICL植入手术及硬性透氧性角膜接触镜治疗青少年近视,均取得良好地效果。其中全省眼科知名专家、主任医师、硕士研究生导师白宁艳教授,主任医师、徐浩教,主任医师、吕鹏教授获近视眼飞秒手术全球认证及近视眼ICL手术全球认证,该领域人才储备充裕。截至目前,已为我州上万名近视患者成功施行了近视手术,让他们完美摘镜。现已形成具有自身特色和专科优势的学科,成为在省内具有一定影响力的眼科团队。肩负着全州近视眼筛查防治及健康教育、近视眼手术质量控制的重任。
白内障 在全省地州级医院中,率先开展白内障手术。可熟练完成葡萄膜炎合并白内障,青光眼合并白内障,过熟期白内障,晶状体脱位伴白内障等复杂白内障的手术治疗。长期肩负着全州白内障复明工程的重任。每年免费为农合及城镇干居民白内障患者实行白内障手术。近十年来,完成白内障手术三万余例。
眼底病诊治 在全省地州级医院中,率先开展玻璃体视网膜手术。能成熟开展复杂视网膜脱离,糖尿病视网膜病变合并牵引性视网膜脱离等玻璃体视网膜手术治疗。在全省眼底病诊治水平处于领先地位。
眼表疾病 能开展真菌性角膜炎、眼表化学伤、角膜穿孔和铜绿假单胞菌性角膜炎等疑难危重症的诊治,可开展穿透性角膜移植术。
青光眼学科 紧跟国内外诊治先进水平,开展了青光眼阀植入手术;开展了新生血管性青光眼,急性闭角型青光眼,恶性青光眼等难治性青光眼的治疗。
眼外伤 有较强的处理疑难危重眼外伤的能力,如陈旧眼内异物、濒危眼外伤、合并颅脑损伤的眼外伤、感染性眼内炎和损伤性视神经病变等。
眼眶疾病 黔西南州人民医院眼科在眼眶手术治疗方面展现出了卓越的能力与特色。对于眼眶肿瘤,无论是良性肿瘤如眼眶海绵状血管瘤、泪腺混合瘤,还是恶性肿瘤如眼眶横纹肌肉瘤等,都能够依据肿瘤的性质、大小、位置等因素,采用合适的手术入路进行切除,并能最大程度地保留患者的视功能和眼部外观。在眼眶骨折修复手术方面,能够进行精准的复位和固定,恢复眼眶的正常结构和容积,改善患者因骨折导致的眼球内陷、复视等症状。目前在全州乃至全省都处于领先水平。
我们将致力于优化专科结构、保持已有优势。按照专科带动、突出特色、发挥优势、科学发展的建设思路,努力打造专业学科品牌,大力推进专科建设。形成具有自身特色和专科优势的学科。努力将科室打造成为在省内有一定影响力的集临床、科研、教学、保健和防盲治盲为一体的眼科中心。
近视防控宣讲

飞秒手术前宣教

人才引进签约

内镜下眼眶手术

高难度的黄斑裂孔手术

屈光白内障手术

Copyright 黔西南布依族苗族自治州人民医院 All Rights Reserved.
黔ICP备17001746号贵公网安备 52230102000043号